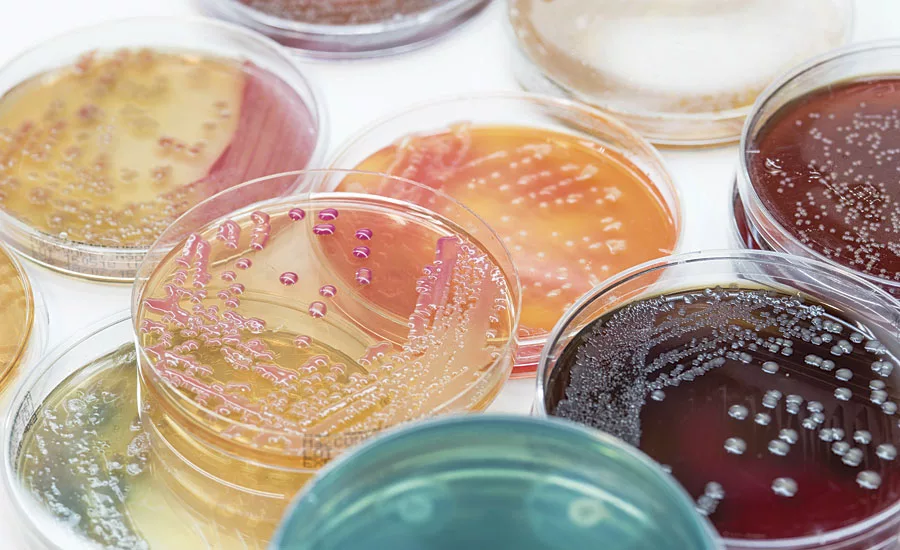
Advances in Antimicrobial Strategies via Smart Chlorine Reservoir Polymers

Advances in Antimicrobial Strategies via Smart Chlorine Reservoir Polymers
The cost of microorganisms to society is a significant issue across many fronts. Microorganisms such as bacteria, yeast and fungi are prolific and often necessary in all aspects of our lives. However, certain species are known to transmit illness to humans, degrade infrastructure and spoil goods. In the United States it is estimated that, on average, the direct cost of a bacteria-related recall to a food processor will be $10 M.1 In a specific case, five days after a recall announcement a publicly traded firm lost $109 M in equity value.2 In 2016, the food industry saw a reported 196 recalls attributed to listeria contamination, 99 recalls related to Salmonella and 31 E. coli associated recalls.3 Therefore, it is reasonable to conclude that the food industry remains interested in advances in microorganism control.
Another industry that is suffering from bacterial contamination is healthcare. Contaminated surfaces and clothing in the healthcare industry have also been shown to contribute to the spread of microbial pathogens within the hospitals. A study investigating the impact of biocide-impregnated linens in a long-term-care brain injury ward found accumulative cost savings of approximately 24% due to reduced antibiotics, fever days and health care-associated infections.4
What about the pipes? The annual cost of corrosion in the United States has been estimated at $276 B, with $36 B of damage occurring in drinking water and sewer systems, and $7 B of damage related to gas and liquid transfer infrastructure.5 It is well known that bacteria can accelerate the corrosion process in metallic- and polymer-coated pipes, leading to reduced service life.
Technology Overview
The key step in combating microbial growth on sensitive surfaces is to provide long-lasting, broad-spectrum killing power. Current technologies based on silver and isothiazolone are impregnated into coatings and require diffusion out of the coating to kill bacteria. This leads to a limited life cycle of the biocidal action with limited modes of action. Exigence Technologies has taken an innovative approach to functionalizing polymer surfaces with its SymbiCoat™ responsive monomers to defend against microbes. By stabilizing and therefore storing an oxidizing agent (such as chlorine found in household bleach, which is commonly used in water treatment, food processing, healthcare and industrial water storage) a new functionality can be added to a variety of polymer systems. The technology is based on the N-halamine molecular functionality, where a N-H bond can freely exchange the hydrogen with a partially charged halogen. Chlorine is a well-known, broad-spectrum sanitizing agent used for liquid disinfection in many commercial products, mainly delivered as sodium hypochlorite and hypochlorous acid in dilute solutions of water. This technology works by stabilizing the free chlorine available in aqueous solutions via a N-chloramine structure, allowing the chlorine to be stored for later use upon contact with bacteria. The innovation of SymbiCoat monomers is the use of cationic centers to increase the microbial efficacy and increase the rate of N-H to N-Cl conversion. When the monomers are incorporated into a polymer, the surface is functionalized as a chlorine reservoir, providing responsive action to bacteria contacting the polymer surface. The stored chlorine is transferred for biocidal action against the bacteria upon contact, and the N-chloramine reverts to an N-H bond. Recharging to a N-Cl occurs when the surface is exposed to a dilute bleach solution (Figure 1).
FIGURE 1 » Reaction scheme for N-halamine interaction with bacteria and sodium hypochlorite.
The technology is ideal in situations where free chlorine is present in sanitizing agents, water supply and in cleaning solutions. The advantages of using chlorine over other biocides include broad-spectrum efficacy, well-understood mechanisms and existing infrastructure, and operational regulations. In many environments and industries, chlorinated solutions are required by internal quality control protocols, and in some cases by law, to be used for cleaning and in general maintenance operations. The beauty of this strategy is the use of existing liquid chemistry to add a sustainable functionality over a coating’s service life.
Antimicrobial Test Methods
To understand the advantages and functionality of the technology it helps to understand how antimicrobial efficacy is measured. Microbial growth or the converse of microbial reduction can be measured by counting the number of colony forming units (CFU). In theory, the CFU is a collection of cells that derived from a single viable cell. The CFU unit is usually measured per volume, area or weight. Due to the size of individual bacteria, many test methods calculate the existing bacteria via logarithmic scale of the CFU. When testing surfaces or textiles, a known amount of bacteria (CFU/mL) are exposed to the activated surface, recovered after a specified period of time and cultivated. Once the bacteria have been cultivated, the reduction in bacteria caused by the surface interaction can be calculated. Typically, the plate count is linear over a range of CFU, and to ensure CFU measurements can be made over this range a serial dilution is used. Figure 2 is an example of a serial dilution of the bacteria concentration in a control sample.
FIGURE 2 » Control agar plate describing colony forming unit.
The results reported in this evaluation will be quantified by the calculated log reduction. Table 1 provides an example of the relationship between % reduction, logarithmic reduction and the number of colony forming units. This is a reference to readers with previous experience dealing with CFU data regarding in-can biocide performance.
TABLE 1 » Bacteria reduction equivalency chart.
The methods utilized in this study are AATCC 100: Antimicrobial Finishes on Textile Materials for Textiles, and ISO 22196: Measurement of Antimicrobial Activity on Plastic Surfaces. These methods provide the conditions applicable to contact killing mechanisms.
What about a realistic commercial situation versus a lab test method? Hospitals, pipes and factories are dirty places. Traditional antimicrobial chemistries will interact with organic matter such as proteins, which in turn impacts the antimicrobial activity. Depending on the mechanism responsible for the antimicrobial efficacy, the performance may be negated by fouling or neutralization by the addition of organic matter. The true test to an antimicrobial technology is the effectiveness in the presence of organic load to demonstrate the commercial potential of the antimicrobial material technology. The SymbiCoat technology has shown encouraging antimicrobial activity in the presence of organic loads.
Textile Studies
Exigence has developed a process to incorporate the chlorine-stabilizing molecules within a variety of commercially available finishing coatings for fabrics. The base fabric chosen for this study was a woven 65/35 poly-cotton from TestFabrics, Inc. Two systems were studied for chlorination kinetics and subsequent antimicrobial performance with the treated fabrics. The textiles were coated through a pad-dry-cure process with a 2 min dry at 105 °C followed by a 2 min cure at 140 °C (Table 2).
TABLE 2 » Textile fabric descriptions.
The chlorination kinetics were studied via a DPD (N,N-diethyl-p-phenylenediamine) method. This method is a colorimetric method designed to use readily available kits to determine free/active chlorine. Figures 3 and 4 represent the conversion of the N-H bond to N-Cl of the N-halamine versus time. The results indicate the expected saturation time for each formulation when subjected to 100 ppm dilute bleach solution.
FIGURE 3 » Percent conversion versus time for F1 when subjected to 100 ppm chlorine solution.
FIGURE 4 » Percent conversion versus time for F2 when subjected to 100 ppm chlorine solution.
Figure 3 and Figure 4 illustrate the unique chlorination kinetics of each formulation. Chlorination kinetics have a dependency on the concentration of available free chlorine, and for the purposes of this study 100 ppm was utilized as a baseline. For instance, in the case of a hospital environment, hot water washing can be attributed to 10-15% of the total energy used by a hospital,6 and even in the case of hot water washing, chlorine bleach is still used to add a margin of safety. It is recommended by the Centers for Medicare and Medicaid Serves that low-temperature washing at 71-77 °F should be used in combination with 125 ppm chlorine bleach. The CDC also recommends that 50-150 ppm is effective at various temperatures during laundering.6,7
Fabric Antimicrobial Test Method
The antimicrobial performance was evaluated using AATCC 100: Antimicrobial Finishes on Textile Materials with minor adaptation. In this test method CA-MRSA 40065 (gram-positive organism), and E. coli 25922 (gram-negative organism) were used as the challenging bacterial species. A standardized density of bacteria (1-2 x 106 CFU/mL) was used for the challenge inoculation. The baseline test inoculum used a phosphate buffer solution (PBS). To evaluate the effect of organic load on antimicrobial activity and efficiency, 5% Trypto soya broth (TSB) was added to the challenging inoculum. For each treatment, two fabric swatches (1 × 1 inch) were placed in contact with 100 µL of bacterial suspension and incubated at various time points. The fabric samples were tested within 60 min rather than 24 hrs as stated in the test method, due to the rapid killing efficiency of SymbiCoat technology. After incubation, neutralizer was added, and samples were vortexed and sonicated to suspend any survivors from the samples. A viability count was performed by dilution and plating on Trypton soya agar (TSA) plates with incubation at 37 °C for 24 hrs.
Fabric Results
Control samples were tested at a 1 hr contact time to provide a baseline for unchlorinated and virgin fabric performance. The chlorinated samples of F1 and F2 fabrics were tested at various time points against both CA-MRSA 40065 and E. coli 25922 in the presence and absence of organic load. The chlorinated F1 samples showed total killing within 10 min against both bacterial strains, whereas chlorinated F2 samples exhibited total killing in 5 min. In presence of organic load (5% TSB) chlorinated F1 showed total killing in 30 min, however chlorinated F2 performed faster and killed all the bacteria in 10 min (Table 3, Figures 5-6).
TABLE 3 » Control samples challenged against E. coli and MRSA in PBS with a 60-min contact time.
FIGURE 5 » Fabric testing of F1 and F2 chlorinated samples against E. coli 25922 and CA-MRSA 40065 in PBS.
FIGURE 6 » Fabric testing of F1 and F2 chlorinated samples against E. coli 25922 and CA-MRSA 40065 in 5% TSB.
Epoxy Studies
To functionalize a metallic surface coating with the N-halamine functionality, novel crosslinking agents were developed to polymerize with a commercial waterborne epoxy. The boundary conditions used for this study reflect the food processing environment and the difficulty in dealing with proteins and other organic materials that are known to decrease the effectiveness of antimicrobial agents. The novel crosslinking agents were designed to provide two levels of performance profiles to meet application-specific criteria, with the second-generation crosslinking agent showing improved performance in organic load conditions. Coatings were coated on galvanized steel substrates and cured at 90 °C for 3 hrs to ensure a fully cured matrix (see Table 4 for a description of the systems used). To further verify that the polymer surface did not produce leaching agents that could contribute to biocidal action, a zone of inhibition test was conducted. The zone of inhibition is a commonly used method in microbiology to test a solution’s toxicity or biocidal tendency to specific bacteria. The results indicated that both E1 and E2 formulations did not have leaching agents that would effect the antimicrobial testing.
TABLE 4 » Epoxy formulation summary.
In the United States and Canada, a maximum of 200 ppm of active chlorine is permitted for sanitizing processing and food-handling equipment without requiring a subsequent rinse prior to food contact. To ensure a feasible application of this technology in the food processing industry, a maximum of 200 ppm active chlorine in an aqueous solution was used to activate the N-halamine moieties on the polymer surface. The DPD method was used to study the conversion kinetics of the E1 surface at a 200 ppm concentration (Figure 7).
FIGURE 7 » Percent conversion versus time for E1 when subjected to 200 ppm.
Epoxy Antimicrobial Test Method
Antimicrobial activity of the coating was tested as per standard ISO 22196 test method with minor adaptations - the samples were tested after 30 min rather than 24 hrs. Coupons (5 x 5 cm) were extracted from the coated galvanized steel and challenged with 200 µL of bacterial suspensions (106 CFU/mL) in presence of various organic loads (5% FBS, MH broth and 5% FBS+nutrient broth), after which the surface was covered with a 4 × 4 cm plastic film. Once the inoculum was applied to the surface, the samples were incubated for 30 min at room temperature. Neutralizer was added and the samples were sonicated for 1 min to suspend viable bacteria from the samples. A viability count was performed by dilution and plating on TSA plates.
Epoxy Results
The testing of the epoxy formulations cured with Symbi-Coat novel chemistries have shown significant killing efficacy within 30 min of contact. Figure 8 indicates a full bacteria reduction in 30 min with both chemistries in 5% FBS. The test results revealed that the E2 samples had a significant advantage over the E1 samples in high organic load inoculum. The E2 formulation utilized enhanced design features to mitigate the unwanted impact of organic load, and indeed the results have supported the design intention. The unchlorinated samples and the galvanized steel have shown no significant antimicrobial activity within 30 min (Table 5).
FIGURE 8 » Testing of E1 and E2 chlorinated samples against E. coli 25922 in various conditions.
TABLE 5 » Control samples challenged against E. coli with a 30-min contact time.
Discussion
The main purpose of this article is to identify the advantages and performance that can be obtained through utilizing functional surfaces acting as chlorine reservoirs. In the instances of organic load conditions, it is often difficult to provide high levels of bacteria killing efficacy due to protein adsorption and the interaction between various biological materials with the surface chemistry. The goal of this technology is to target the bacteria and repel the protein and other biofilm-forming materials. The main issue with cationic materials is that they tend to allow protein adsorption, which in turn can produce a monolayer of organic material, causing any contact-based surface technology to become ineffective. Preliminary testing has indicated ~70% reduction in protein absorbance on surfaces of E2 over E1 when subjected to a MH broth solution, confirming the ability of the technology to target bacteria-to-surface interactions. Ongoing development activities are therefore targeted to develop a coating that is not only responsive to bacteria, but also responds to the organic environment that the bacteria are living in.
This technology has shown to be versatile in application and effective at providing chlorine-based efficacy in challenging environments. The next phase of implementation requires specific commercial chemistries to be evaluated that target a specific industrial environment.
References
1 Grocery Manufacturers Association, Deloitte Development LLC. Recall Execution Effectiveness: Collaborative Approaches to Improving Consumer Safety and Confidence (2010). Retrieved from http://www.gmaonline.org.
2 Pozo, V.F.; Schroeder, T.C. Costs of Meat and Poultry Recalls to Food Firms. All Current Publications. Paper 687 (2015).
3 Maberry, T. A Look Back at 2016 Food Recalls. Food Safety Magazine. (2017, February, 7). Retrieved from http://www.foodsafetymagazine.com.
4 Lazary, A.; Weinberg, I.; Vatine, J.J.; Jefidoff, A.; Bardenstein, R.; Borkow, G.; Ohana, N. Reduction of Healthcare-Associated Infections in a Long-Term Care Brain Injury Ward by Replacing Regular Linens with Biocidal Copper Oxide Impregnated Linens. International Journal of Infectious Diseases, (2014) 24, 23-29.
5 Koch, G.H.; Brongers, M.P.H.; Thompson, N.G.; Virmani, Y.P.; Payer, J.H. Corrosion Costs and Preventative Strategies in the Unites States. NACE International, FHWA-RD-01-156.
6 Sehulster, L.M.; Chinn, R.Y.W.; Arduino, M.J.; Carpenter, J.; Donlan, R.; Ashford, D.; Besser, R.; Fields, B.; McNeil, M.M.; Whitney, C.; Wong, S.; Juranek, D.; Cleveland, J. Guidelines for Environmental Infection Control in Health-Care Facilities. Recommendations from CDC and the Healthcare Infection Control Practices Advisory Committee (HICPAC). American Society for Healthcare Engineering/American Hospital Association (2004).
7 Centers for Medicare & Medicaid Services. Clarification of Interpretive Guidance at F Tag 441-Laundry and Infection Control [Memo # 13-09-NH]. (2013, January 25). Retrieved from https://www.cms.gov.
Looking for a reprint of this article?
From high-res PDFs to custom plaques, order your copy today!





